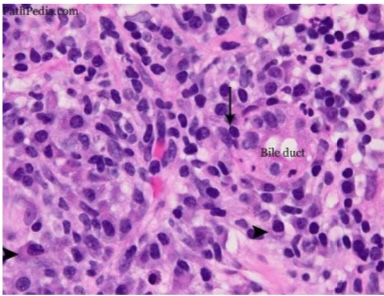
term image
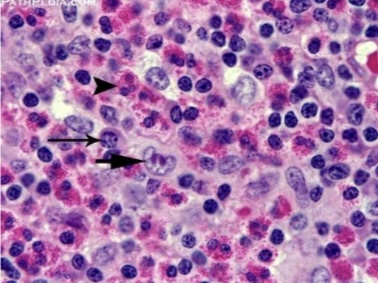
term image

1/26
Looks like no tags are added yet.
Name | Mastery | Learn | Test | Matching | Spaced | Call with Kai |
|---|
No analytics yet
Send a link to your students to track their progress

exudative inflammation

catarrhal inflammation

serous inflammation

diphtheritic inflammation

purulent inflammation

granulomatous inflammation

fibrinous inflammation

interstitial inflammation

parenchymatous inflammation
non-suppurative inflammation

pseudomembranous inflammation

hemorrhagic inflammation

mucoid inflammation

necrotizing inflammation
eosinophilic inflammation

pyogranulomatous inflammation

lymphohistiocytic inflammation

granuloma

lymphohistiocytic inflammation

repair by regeneration

granulomatous inflammation

repair by substitution

pyogranulomatous inflammation

cells of lens

fibroblasts

cheek epithelial cells

granulation tissue